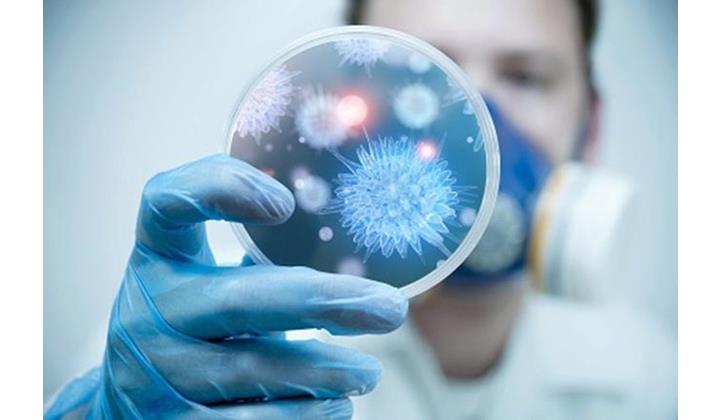

В пресс-службе управления Роспотребнадзора по РД сообщили, что массовый отказ от вакцинации от полиомиелита существенно повышает риск возникновения эпидемии.
Также сообщается, что в прошлом году в Дагестане выявили 20 случаев острого вялого паралича. Во всех случаях исследование на полиомиелит дало отрицательный результат.
Однако на сегодняшний день в республике наблюдается «напряженная эпидемиологическая ситуация», и всё из-за того, что свыше 18 тысяч детей не получат прививку от полиомиелита по решению своих родителей.
К сказанному в Роспотребнадзоре добавили, что данный показатель относится к первым двум месяцам текущего года и вдвое превышает показатель аналогичного периода прошлого года.
Мурад Саидов